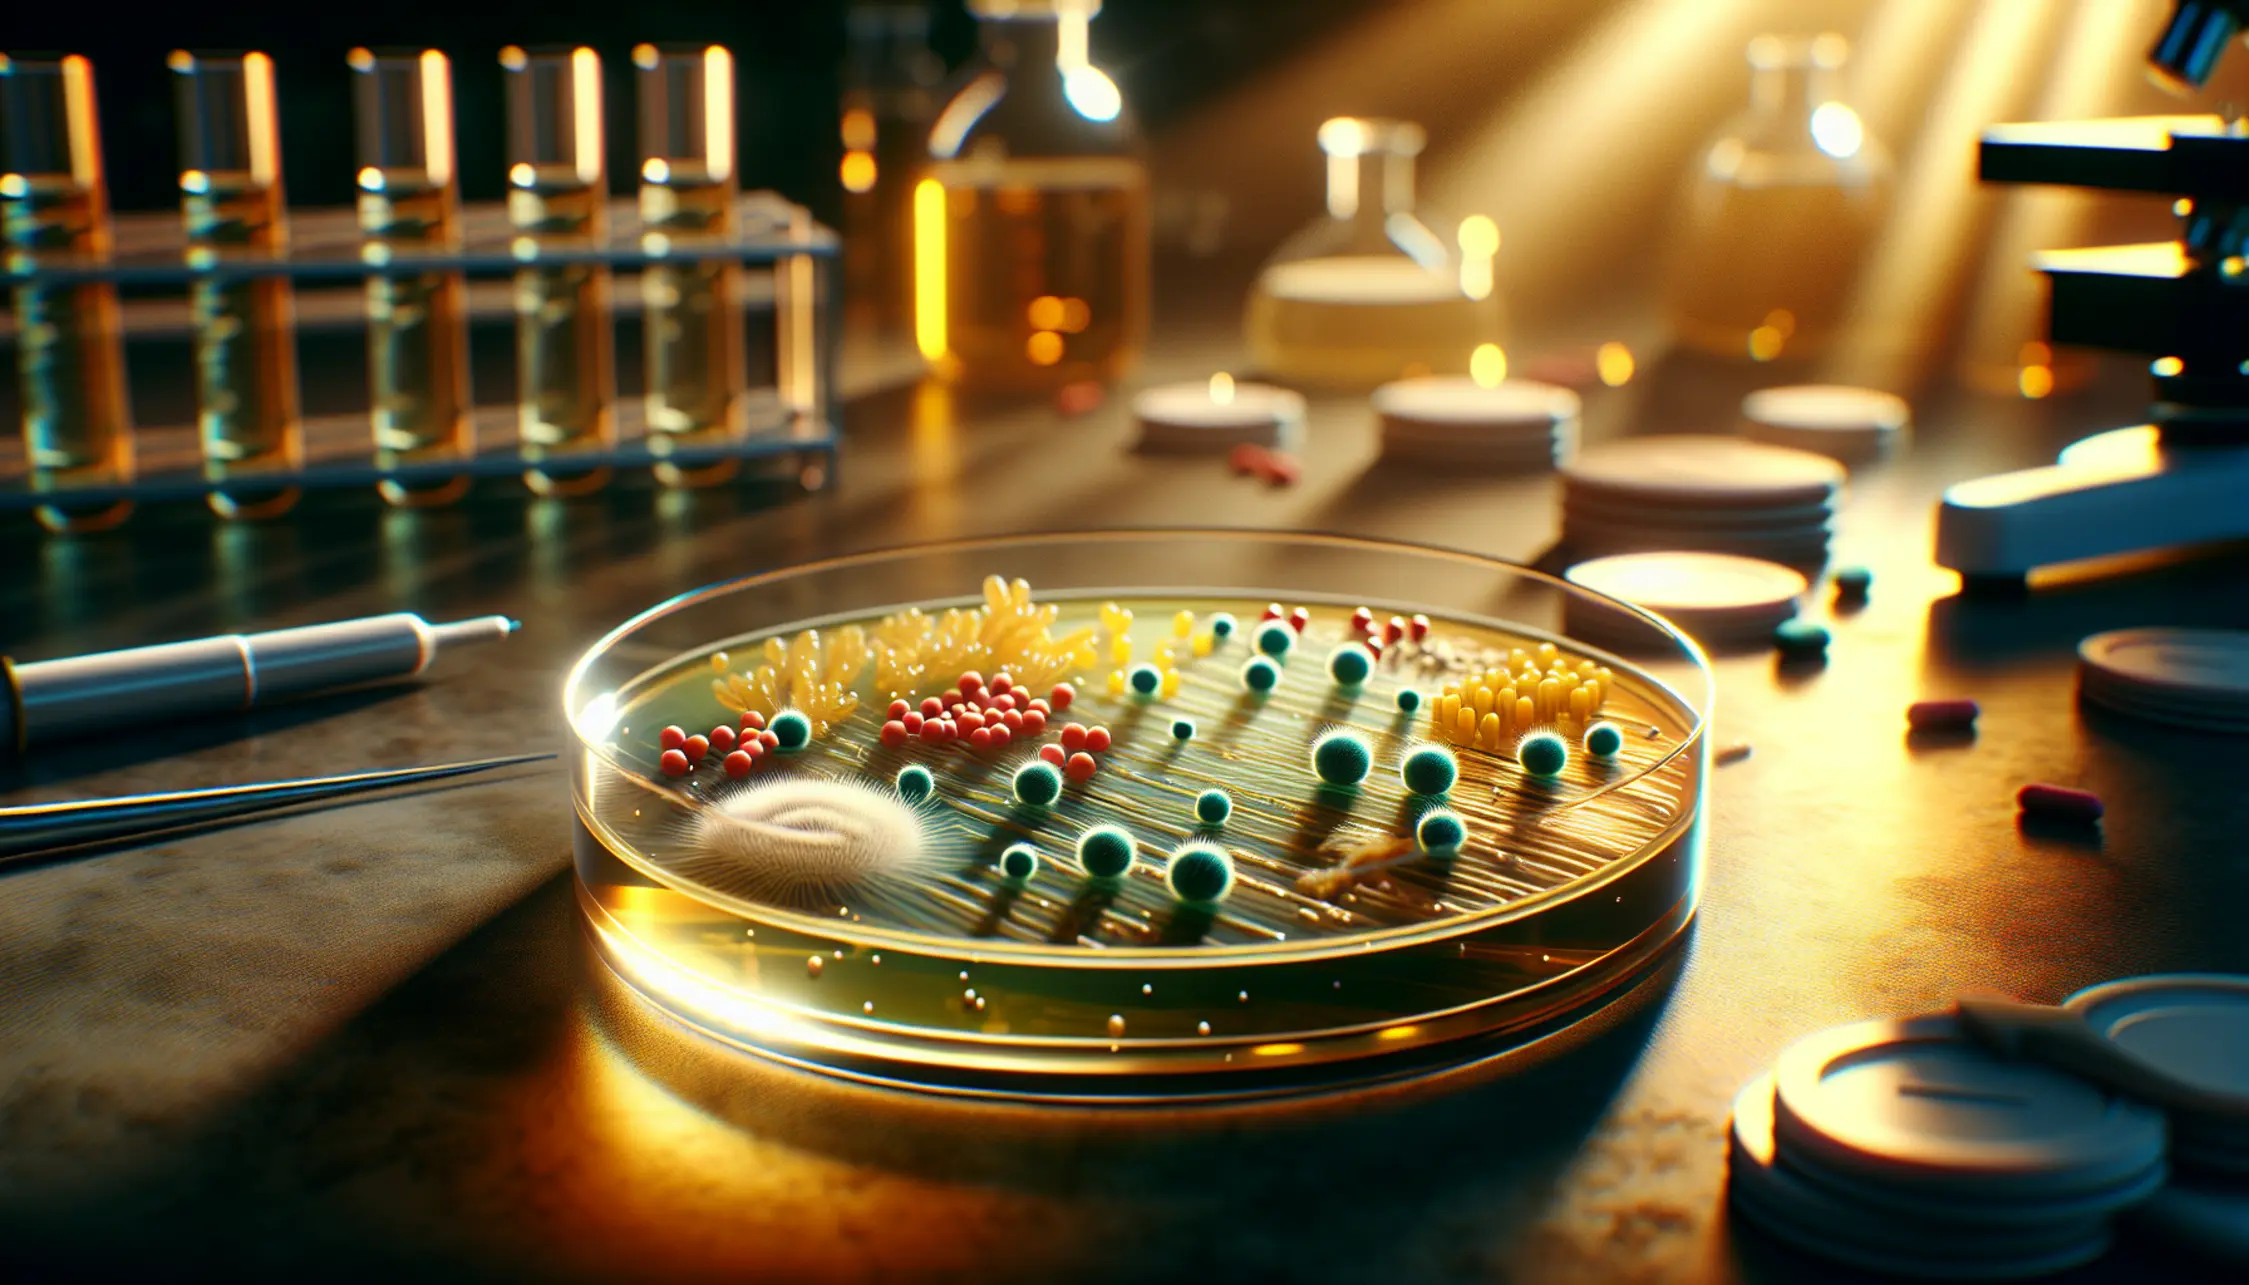
Cosa sono i batteri resistenti agli antibiotici?

Cosa sono i batteri resistenti agli antibiotici?
Vi è mai capitato di pensare che quella pillolina che prendiamo per stare meglio, il nostro caro antibiotico, un giorno possa diventare inefficace? Tipo un supereroe che ha perso i suoi superpoteri? Eh già, perché oggi parliamo di una cosa seria, ma cerchiamo di farlo con un sorriso, come si fa al bar davanti a un caffè. Stiamo per svelare il mistero dei batteri resistenti agli antibiotici, una sfida che mette a dura prova la medicina moderna e che ci riguarda tutti da vicino. Perché capirlo non è solo per scienziati in camice bianco, ma per chiunque voglia continuare a contare su una cura efficace per le tante infezioni che, diciamocelo, a volte ci assalgono senza preavviso. Siete pronti a scoprire perché questo fenomeno è più “rock and roll” di quanto sembri? Andiamo!
I batteri: piccoli, ma con una grande attitudine alla sopravvivenza
Dunque, mettiamola così: i batteri sono un po’ come i nostri coinquilini invisibili. Alcuni sono bravi, ci aiutano persino (pensate a quelli nell’intestino, fondamentali per la digestione!), altri invece sono dei veri e propri vandali, che ci fanno star male con le loro malefatte, provocando infezioni che vanno dal banale mal di gola a cose ben più serie. Per combattere questi “vandali”, abbiamo scoperto e sviluppato gli antibiotici, delle armi potentissime che hanno cambiato la storia della medicina, salvando innumerevoli vite. Pensate che prima della loro scoperta, un’infezione batterica poteva essere una condanna a morte! Mica uno scherzo.
Ma questi piccoli esserini, così semplici nella loro struttura, hanno un’arma segreta: la resistenza. È come se, davanti a un attacco, sviluppassero un antidoto da soli. Inizialmente, un antibiotico fa il suo sporco lavoro, stermina la maggior parte dei batteri “cattivi”. Tuttavia, alcuni batteri, per puro caso o grazie a piccole mutazioni genetiche, riescono a sopravvivere. Questi “sopravvissuti”, invece di soccombere, si moltiplicano, e voilà: la nuova generazione di batteri è immune a quell’antibiotico specifico. È una selezione naturale in salsa microscopica, dove il più forte (in questo caso, il più resistente) vince.
La resistenza: come i batteri diventano “invincibili”
E qui casca l’asino, o meglio, qui si complica la faccenda. La resistenza agli antibiotici non è una cosa che nasce dal nulla. È un processo evolutivo che i batteri mettono in atto in modo sorprendentemente efficace. Come dicevamo, le mutazioni genetiche sono il motore principale. Immaginate che un batterio, per un colpo di fortuna genetica, sviluppi una piccola “armatura” che lo protegge dall’attacco dell’antibiotico. Quando questo batterio si riproduce, trasmette la sua “armatura” ai suoi discendenti. Se poi questi batteri entrano in contatto con l’antibiotico, saranno proprio loro a prosperare, mentre i batteri sensibili soccombono.
Ma non finisce qui. I batteri sono anche dei grandi “scambisti”. Possono letteralmente scambiarsi informazioni genetiche, compresi i geni che conferiscono la resistenza. È un po’ come se si passassero il manuale di autodifesa: “Ehi, ho scoperto come fregare questo antibiotico, te lo copio!”. Questo scambio di informazioni può avvenire tra batteri della stessa specie, ma anche tra specie diverse, accelerando enormemente il processo di diffusione della resistenza. È un po’ come se, invece di aspettare di evolversi uno per uno, si dessero una bella mano.
Fattori che accelerano la resistenza
Purtroppo, noi umani non siamo sempre stati dei bravi ragazzi con gli antibiotici. Il loro uso eccessivo e, diciamocelo, spesso inappropriato, ha dato una bella spinta a questo fenomeno. Quante volte ci è capitato di sentire o dire: “Ho una tosse, mi dia un antibiotico”. Ecco, la tosse, nella maggior parte dei casi, è virale, e gli antibiotici sui virus non fanno assolutamente nulla. Il risultato? Si usano farmaci potenti per niente, e si stressano inutilmente i batteri, spingendoli a sviluppare resistenza.
Questo vale sia per la medicina umana che per quella veterinaria. L’uso diffuso di antibiotici negli allevamenti, ad esempio, per “prevenire” malattie in condizioni spesso non ottimali, è un altro fattore chiave che contribuisce alla creazione di “superbatteri”. E pensate che questi batteri, una volta sviluppata la resistenza in un animale, possono poi passare all’uomo attraverso il cibo o il contatto diretto. Insomma, un circolo vizioso che è bene conoscere per interromperlo.
| Situazione | Antibiotico A | Resistenza |
|---|---|---|
| Anno 0: Batteri “normali” | Molto efficace | Rara (mutazione casuale) |
| Anno 5: Uso frequente Antibiotico A | Meno efficace | Presente nel 10% dei batteri |
| Anno 10: Uso massiccio Antibiotico A | Inefficace | Diffusa nel 70% dei batteri |
| Anno 15: Tentativo con Antibiotico B | Potrebbe funzionare (se diverso) | Potrebbe già esistere resistenza incrociata |
Le conseguenze: un futuro con poche cure?
E qui arriviamo al dunque. Cosa significa tutto questo per noi? Significa che le infezioni che oggi curiamo con relativa facilità potrebbero diventare in futuro molto più difficili, se non impossibili, da trattare. Immaginate di dover affrontare un’operazione chirurgica, un trapianto d’organo, o semplicemente una polmonite, e di non avere antibiotici efficaci per prevenire o curare le infezioni batteriche che potrebbero insorgere. Le procedure mediche che oggi diamo per scontate potrebbero diventare estremamente rischiose.
Questo fenomeno, noto anche come “emergenza dei superbatteri”, non è una minaccia lontana, ma una realtà che stiamo già vivendo. Ci sono già batteri resistenti a quasi tutti gli antibiotici disponibili, costringendo i medici a ricorrere a trattamenti più tossici, costosi e meno efficaci, o, nei casi peggiori, a non avere più opzioni terapeutiche. È un po’ come trovarsi in un negozio di armi e scoprire che la maggior parte delle spade sono arrugginite e gli scudi bucati. Non è proprio un quadro rassicurante.
Cosa possiamo fare noi? Un piccolo sforzo, un grande aiuto
La buona notizia è che, nonostante la complessità del problema, ognuno di noi può fare la sua parte. Il primo passo è usare gli antibiotici solo quando sono veramente necessari e prescritti dal medico. Niente automedicazione, mi raccomando! Se il dottore vi dice che la vostra è un’infezione virale, fidatevi e resistete alla tentazione di chiedere una “ricetta magica” che non servirà a nulla se non a favorire la resistenza.
Un altro punto fondamentale è completare sempre l’intero ciclo di terapia antibiotica prescritto, anche se vi sentite meglio dopo pochi giorni. Interrompere la cura troppo presto significa lasciare in vita i batteri più resistenti, che potranno poi moltiplicarsi. È come lasciare un piccolo gruppo di ribelli attivi dopo aver sconfitto il grosso dell’esercito. Fate attenzione anche all’igiene personale: lavarsi le mani spesso è un modo semplice ma efficace per prevenire la diffusione di infezioni, riducendo la necessità di antibiotici. Quindi, mani pulite, testa sulle spalle e antibiotici con giudizio!
Domande frequenti
Perché i batteri diventano resistenti agli antibiotici?
I batteri sviluppano resistenza attraverso mutazioni genetiche casuali o scambiando geni tra loro. L’uso eccessivo e inappropriato degli antibiotici da parte dell’uomo favorisce la sopravvivenza e la moltiplicazione di questi batteri resistenti, portando a una vera e propria “evoluzione” in corso.
Gli antibiotici funzionano contro i virus?
Assolutamente no! Gli antibiotici sono specifici per combattere i batteri. I virus, essendo organismi completamente diversi, non sono influenzati dagli antibiotici. Usarli contro le infezioni virali è inutile e dannoso, perché contribuisce alla resistenza batterica.
La resistenza agli antibiotici è contagiosa?
La resistenza in sé non è contagiosa nel senso che non si “prende” come un raffreddore. Tuttavia, i batteri che possiedono geni di resistenza possono diffondersi da persona a persona, attraverso il contatto diretto, le goccioline respiratorie o superfici contaminate, portando con sé la loro capacità di resistere agli antibiotici.
Cosa succede se un’infezione diventa resistente agli antibiotici?
Le infezioni causate da batteri resistenti sono molto più difficili da trattare. Richiedono spesso antibiotici alternativi, che possono essere meno efficaci, più tossici o più costosi. In alcuni casi, non esistono più trattamenti efficaci, rendendo l’infezione potenzialmente letale.



